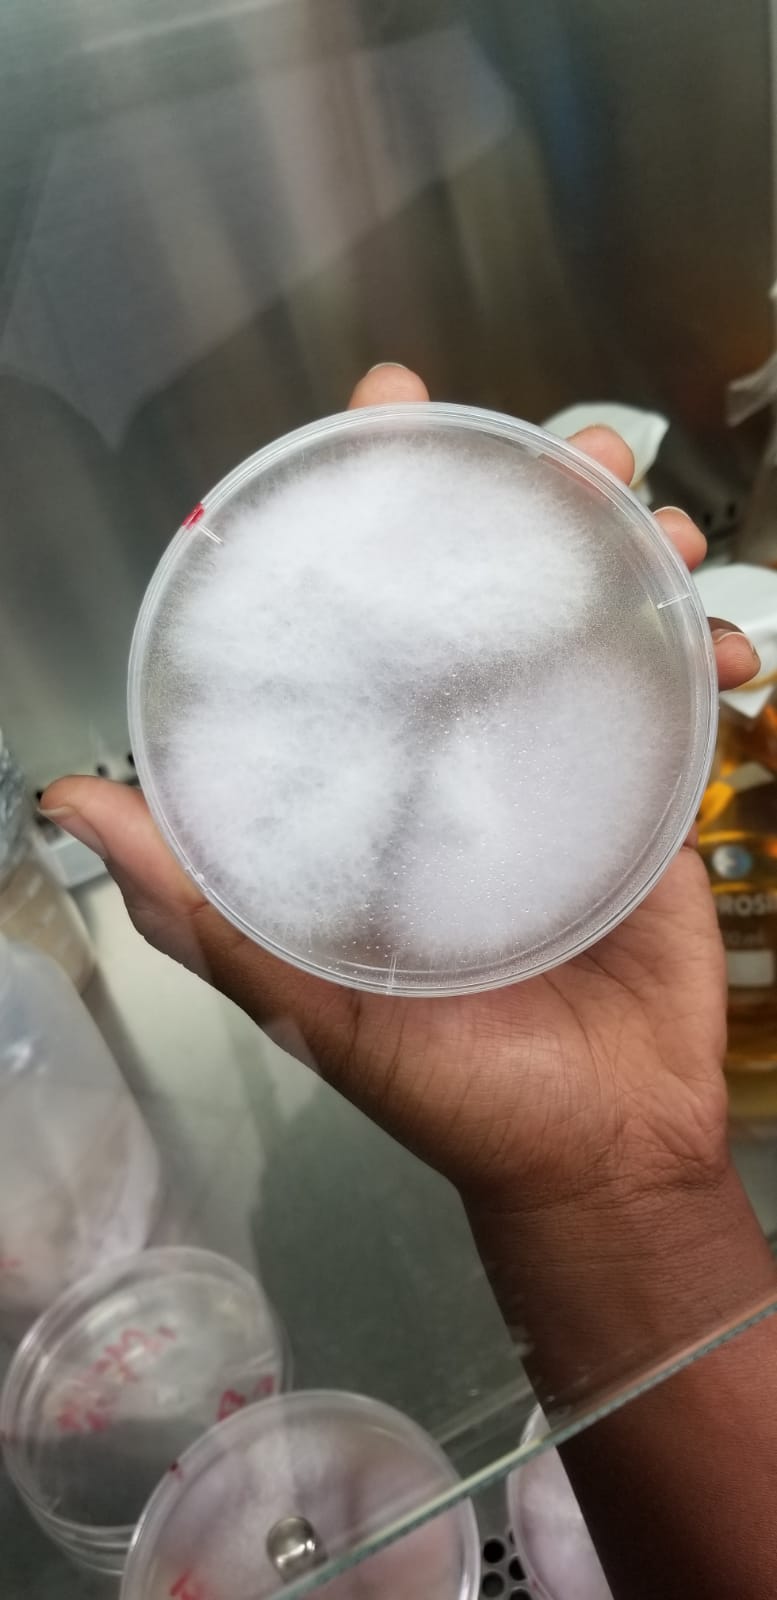

Toothpick Company Limited
Aussteller Woche der Umwelt 2024
Ein biologisches Herbizid an Maissaatgut bekämpft den Hunger in Kenia und anderen Subsahara-Staaten
Das biologische Herbizid „Kichawi Kill“ wurde im September 2021 zur Anwendung in Kenia zugelassen. Das Produkt basiert auf der Wirkung eines Bodenpilzes, der das parasitäre Unkraut Striga hermonthica (auch witch weed, oder Hexenkraut) befällt und abtötet. S. hermonthica kann auf verseuchten Flächen Ertragsverluste von bis zu 100 % verursachen. Der im Produkt verwendete Stamm eines Bodenpilzes (Foxy) wurde speziell hinsichtlich seiner herbiziden Wirkung gegen S. hermonthica selektiert. Er wirkt sehr spezifisch und befällt daher keine andere Pflanzenart. Der Stamm wurde zum Patent angemeldet.Zunächst wurde das Produkt in den kenianischen Dörfern als Granulat hergestellt. Ab Juni 2022 ist jedoch auch ein Saatgutbehandlungsmittel in Kenia zugelassen, mit dem die Anwendung wesentlich einfacher erfolgen kann. Beim Anbau von Mais sind 200 Gramm pro Hektar ausreichend, um die Pflanzen wirkungsvoll vor einem Befall zu schützen.
Striga hermonthica hat schon jetzt die Flächen von ca. 40 Mio. kleinen landwirtschaftlichen Betrieben (Subsistenzfarmen) in Afrika verseucht. Je Pflanze können ca. 200.000 Samen entstehen, die in den Boden gelangen und dort auf den erneuten Anbau einer Wirtspflanze warten. Es wird geschätzt, dass in Afrika ein Ernteertrag von jährlich 10.000.000 t durch den Befall von Mais und Hirse mit dem parasitären Unkraut verloren geht. Der Parasit keimt bei Anbau einer geeigneten Pflanze aus, saugt sich mit seinen Saugorganen an den Wurzeln fest, dringt in die Wurzeln vor und ernährt sich vom Wasser und von den Nährstoffen der Wirtspflanzen.
Der durchschnittliche Ertragszuwachs in 25 landwirtschaftlichen Betrieben betrug 648 Kilogramm pro Hektar. Nach erfolgreicher Einführung des neuen Verfahrens in Kenia soll die Technologie auf andere afrikanische Staaten ausgedehnt werden. Dadurch wird nicht nur die Ernährungssicherheit in Afrika erhöht. Es wird gleichzeitig die Belastung von Mensch und Umwelt mit toxischen chemisch-synthetischen Herbiziden verringert.
Übersicht
Firma
Toothpick Company LimitedPO Box: 2138
50100 Kakamega
Kooperationspartner
KALRO (Kenyan Research and Livestock Research Organization)
Montana State University
Deutsche Welthungerhilfe
Montana State University
Deutsche Welthungerhilfe
Standnr.
54Bilder-Galerie
Video

Bei Klick wird dieses Video von YouTube geladen. Siehe Datenschutzerklärung.